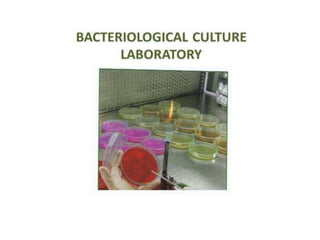
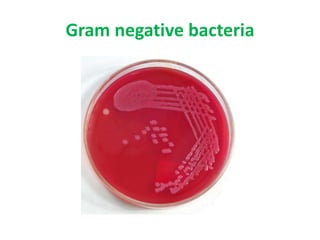
Gram negative bacteria

The document discusses the critical importance of public health chemistry in water analysis, highlighting the need for clean and safe drinking water as a fundamental human right. It details the sources of water contamination, methods for water testing, and the impacts of water quality on human health, emphasizing the necessity for regular monitoring and research in water purification technologies. The presentation also outlines research areas that should be prioritized in the next 10-15 years to enhance water use efficiency and ensure sustainable water quality management.